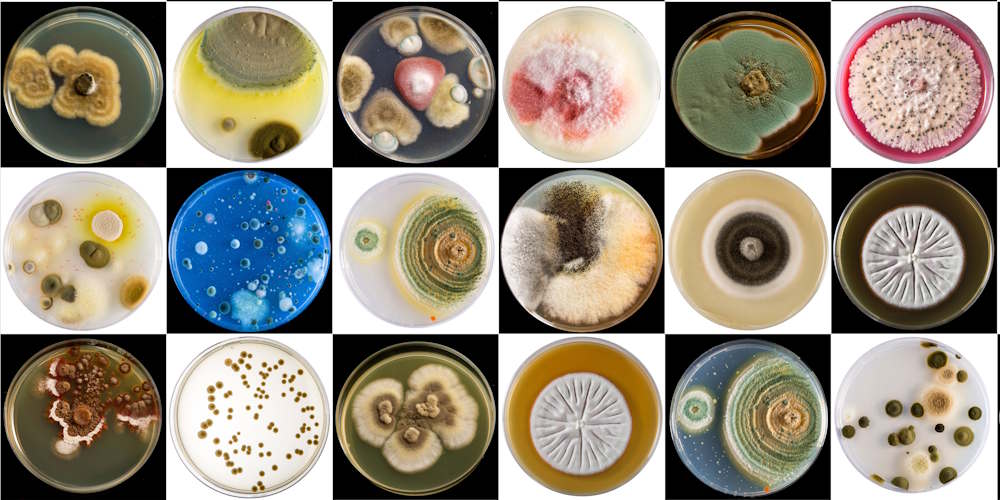

5 ting du skal vide om sygdomsbærende bakterier i din nærhed
Patogener – det er sådan nogen som streptokokker og stafylokokker - findes overalt omkring os. Men de gør os ikke altid syge. Hvornår er de fredelige? Og hvornår er de farlige? Bliv klogere i denne explainer, som er lavet i samarbejde med mikrobiolog Clare Kirkpatrick.
1: De vil dig ikke noget ondt
Ligesom alle andre levende organismer på Jorden er de kun interesseret i at få opfyldt sine behov og føre en stressfri tilværelse.
2: De hader solskin
Solskin er et af de bedste naturlige desinfektionsmidler. UV-lys skader bakteriernes DNA, og derfor bruges det til at desinficere overflader med hyppig berøring på hospitalsstuer. Pga. sollysets UV-stråling er det meget svært for patogener at overleve i miljøer, som er udsat for sollys.
Disse gør os tit syge
(Kilde: Statens Serum Institut)
3: Pludselig går de fra fredelig til farlig
Patogener er alle vegne, men de gør kun skade, hvis de havner det forkerte sted på det forkerte tidspunkt. For eksempel:
- E. coli er ganske ufarlig i vores tarme, hvor de bl.a. holder andre, mere skadelige bakterier i skak. Men finder E. coli vej til urinvejene eller blodbanen, kan man få urinvejsinfektion eller blodforgiftning.
- Stafylokokker kan leve ganske fredeligt på huden og i næsen uden at give problemer, men bliver farlig, hvis den havner i et åbent sår.
- Streptococcus pneumonieae kan også leve fredeligt i næse og svælg, men giver betændelse i lunger og mellemøre, hvis den kommer på afveje. Hvis den finder vej til blod eller hjernehinder, opstår der risiko for meningitis.
4: Din hud er dit skjold
Send din hud en ekstra tanke, for den yder en kæmpe indsats i arbejdet med at forhindre patogener i at kommer ind i din krop. Huden er en effektiv barriere, og det betyder, at langt de fleste patogener skal i kontakt med et åbent sår, et øje, en næse eller en mund for at komme ind og udgøre en trussel.
5: De har naturlige fjender, og en af dem hedder fag
Antibiotika-resistente bakterier er et kæmpe problem. Derfor arbejdes der på at udvikle nye antibiotika eller helt andre metoder til at bekæmpe dem med. På SDU forskes der bl.a. i bakteriofager, som er virus, der specifikt angriber bakterier. Fager findes overalt og mange venter formentlig blot på at blive opdaget og taget i brug. Fx har Clare Kirkpatrick og hendes studerende fundet en i Odense Å, der viste sig at kunne angribe og dræbe den resistente Pseudomonas aeruginosa, som findes på hospitaler.
Mød forskeren
Clare Kirkpatrick er mikrobiolog og lektor ved Institut for Biokemi og Molekylær Biologi. Hendes forskningsgruppe studerer bakteriers stressrespons, særligt DNA‑skadestress, stress i cell-envelope og angreb fra bakteriofager.

